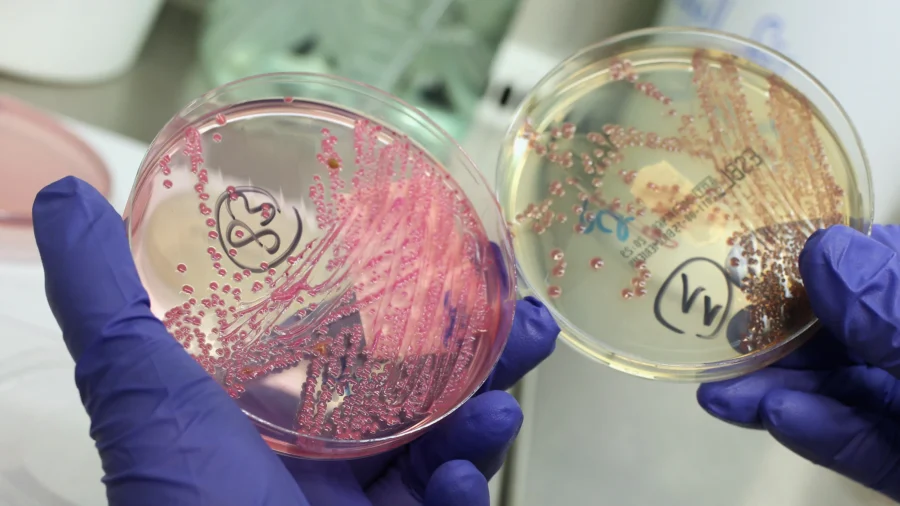
Chinese Researcher Charged With Smuggling E. Coli Into US

Science & Tech
US Grants TSMC Annual Licence to Import Chipmaking Tools Into China
South Korea's Samsung Electronics and SK Hynix have also received similar import licences.

Where US and China Stand in New Space Race to Moon: Analyst
Rick Fisher, senior fellow at the International Assessment and Strategy Center, discussed the space race between the United States and China to land astronauts on the moon.

New York to Require Warning Labels on Social Media Platforms
The law targets infinite scrolling, auto-play videos, and algorithmic feeds that encourage extensive use of social media platforms.

India Launches Its 'Heaviest Satellite' Ever Into Orbit
The Indian Space Research Organization said the satellite has been put into low Earth orbit.
Scientists Reverse Alzheimer's Symptoms in Mice
In mice with advanced disease—animals already suffering significant brain damage—the treatment not only halted the disease's progression but reversed the damage.
Hawaii's Kilauea Volcano Eruption Reaches 1-Year Mark in Spectacular Fashion
Hawaii’s Kilauea volcano eruption reached a 1,000-foot peak for its one-year eruption milestone.
AI-Generated Deepfake Cyberbullying Emerges as New Crisis for Schools Nationwide
Victims often struggle to disprove the fake content because of its realistic appearance, contributing to anxiety, depression, and social withdrawal.
FBI Expands Overseas Biometrics Program
The FBI is expanding its overseas biometrics programs. FBI Director Kash Patel said this will help stop bad actors before they enter the United States.
The Christmas Tree Battle: Real Versus Fake
Christmas is just days away, and the tree farmers who produce holiday trees are dealing with a new reality: They are competing with companies that make artificial trees.
Waymo Robotaxi Fleet Stalls During San Francisco Power Outage
San Francisco suffered large-scale power outages on Saturday that affected 130,000 homes and businesses.
Trump Orders Federal Spectrum Shift to Secure US Lead in Global 6G Race
Analysts say early control over spectrum could determine which countries shape the future digital economy and security environment.
First Wheelchair User Flies to Space on Blue Origin Mission
“It was the coolest experience,” she said shortly after landing.
Chinese Researcher Charged With Smuggling E. Coli Into US
A Chinese researcher on a J-1 visa at Indiana University has been charged after allegedly smuggling E. coli bacteria from China into the United States.
House Sends Land Development Permit Reform Bill to Senate
The proposed SPEED Act narrows the scope of environmental impact studies, accelerates project reviews, and trims litigation timelines.
Tiktok Agrees to Sell US Operations to American-Led Investor Group
The move is a big step to end years of worry about TikTok's future in the United States.
Trump Signs Executive Order to Pursue US Space Superiority
The president said he would prioritize the nation’s push to space for commercial, national security, and exploration purposes.
Musk’s Starlink Says It Lost Communication With One of Its Satellites
The company says it will coordinate with NASA and SpaceX, its owner, to track objects orbiting around the Earth.
Interstellar Comet 3I/ATLAS Makes Historic Close Approach to Earth Friday
After Friday’s flyby, comet 3I/ATLAS will journey farther out through the solar system.
Trump Media to Merge With Nuclear Fusion Company TAE in $6 Billion Deal
Trump Media CEO Devin Nunes will be the co-CEO of the new company, along with TAE CEO Michl Binderbauer.
CCP Exploiting US-Funded Research on Nuclear Technology: Congressional Report
The Chairman of the House Select Committee on the Chinese Communist Party described the situation as ‘deeply alarming.’
US Grants TSMC Annual Licence to Import Chipmaking Tools Into China
South Korea's Samsung Electronics and SK Hynix have also received similar import licences.
Where US and China Stand in New Space Race to Moon: Analyst
Rick Fisher, senior fellow at the International Assessment and Strategy Center, discussed the space race between the United States and China to land astronauts on the moon.
New York to Require Warning Labels on Social Media Platforms
The law targets infinite scrolling, auto-play videos, and algorithmic feeds that encourage extensive use of social media platforms.
India Launches Its 'Heaviest Satellite' Ever Into Orbit
The Indian Space Research Organization said the satellite has been put into low Earth orbit.
Scientists Reverse Alzheimer's Symptoms in Mice
In mice with advanced disease—animals already suffering significant brain damage—the treatment not only halted the disease's progression but reversed the damage.
Hawaii's Kilauea Volcano Eruption Reaches 1-Year Mark in Spectacular Fashion
Hawaii’s Kilauea volcano eruption reached a 1,000-foot peak for its one-year eruption milestone.
AI-Generated Deepfake Cyberbullying Emerges as New Crisis for Schools Nationwide
Victims often struggle to disprove the fake content because of its realistic appearance, contributing to anxiety, depression, and social withdrawal.
FBI Expands Overseas Biometrics Program
The FBI is expanding its overseas biometrics programs. FBI Director Kash Patel said this will help stop bad actors before they enter the United States.
The Christmas Tree Battle: Real Versus Fake
Christmas is just days away, and the tree farmers who produce holiday trees are dealing with a new reality: They are competing with companies that make artificial trees.
Waymo Robotaxi Fleet Stalls During San Francisco Power Outage
San Francisco suffered large-scale power outages on Saturday that affected 130,000 homes and businesses.
Trump Orders Federal Spectrum Shift to Secure US Lead in Global 6G Race
Analysts say early control over spectrum could determine which countries shape the future digital economy and security environment.
First Wheelchair User Flies to Space on Blue Origin Mission
“It was the coolest experience,” she said shortly after landing.
Chinese Researcher Charged With Smuggling E. Coli Into US
A Chinese researcher on a J-1 visa at Indiana University has been charged after allegedly smuggling E. coli bacteria from China into the United States.
House Sends Land Development Permit Reform Bill to Senate
The proposed SPEED Act narrows the scope of environmental impact studies, accelerates project reviews, and trims litigation timelines.
Tiktok Agrees to Sell US Operations to American-Led Investor Group
The move is a big step to end years of worry about TikTok's future in the United States.
Trump Signs Executive Order to Pursue US Space Superiority
The president said he would prioritize the nation’s push to space for commercial, national security, and exploration purposes.
Musk’s Starlink Says It Lost Communication With One of Its Satellites
The company says it will coordinate with NASA and SpaceX, its owner, to track objects orbiting around the Earth.
Interstellar Comet 3I/ATLAS Makes Historic Close Approach to Earth Friday
After Friday’s flyby, comet 3I/ATLAS will journey farther out through the solar system.
Trump Media to Merge With Nuclear Fusion Company TAE in $6 Billion Deal
Trump Media CEO Devin Nunes will be the co-CEO of the new company, along with TAE CEO Michl Binderbauer.
CCP Exploiting US-Funded Research on Nuclear Technology: Congressional Report
The Chairman of the House Select Committee on the Chinese Communist Party described the situation as ‘deeply alarming.’